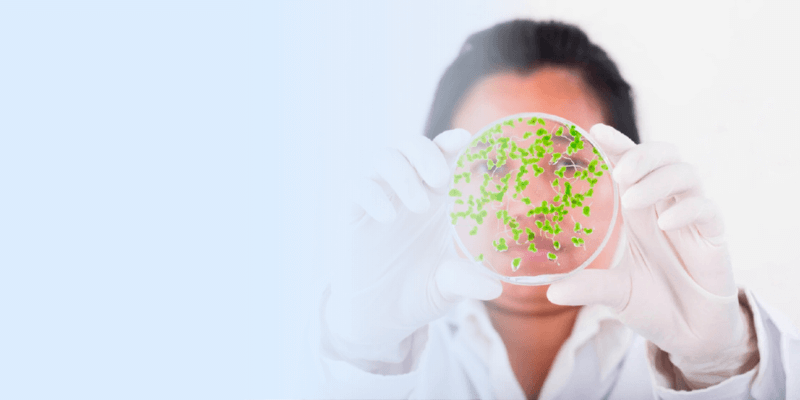
Closeup of scientist and petri dish

Accelerating Research
ZAGENO (pronounced ZAH-GEE-NOH) exists to make lab supply ordering easier, so research scientists can focus on accelerating innovation. Our feature-rich marketplace was designed to facilitate intelligent, streamlined purchasing decisions that help fuel what it’s all about - scientific discovery.

Our Mission
We’re all about those exhilarating eureka moments when research scientists achieve triumphant breakthroughs. These successes are made possible when the right factors converge — a well-equipped lab, efficient time management with less time spent managing supplies, and more time at the lab bench. Creating this environment is at the heart of ZAGENO. As the leading life sciences marketplace, we are meticulously designed to simplify the process of providing research scientists exactly what they need, exactly when they need it.
Our Vision
“Life science has reached an inflection point. For its mission of scientific discovery to succeed and lead to improved health, a confluence of forces must align. ZAGENO was founded on the shared vision that digital aggregation of life science is tied to its long-term potential. Today, our marketplace reduces administrative burden, empowering research scientists to achieve what we call ‘eureka moments.’ We’ve built ZAGENO to serve as the industry’s single source for life science offerings and a springboard for ideas.”
DAVID PUMBERGER, CPO & FLORIAN WEGENER, CEO
Our Leadership
Join Us
Learn MoreOur Management
Join Us
Learn MoreOur Investors




We’re Located in the US and Europe
Three locations, plus a remote team all over the globe
Cambridge, United States
ZAGENO @ WeWork
625 Massachusetts Ave, 2nd Floor
Cambridge, MA 02139
USA
San Francisco, United States
ZAGENO @ WeWork
Two Embarcadero Center, 8th Floor
San Francisco, CA 94111
USA
Bangalore, India
ZAGENO @ WeWork,
Roshni Tech Hub
Marathahalli, BBMP Khatha No. 1395, Sy.No. 26 (P) Marathahalli Main Road, EPIP Zone, Chinnapanna Halli, Bangalore, KA 560037
About ZAGENO
With over 50M+ product SKUs available from more than 6,000 leading brands, ZAGENO offers the largest life sciences lab supply marketplace. Our one-stop-shop solution helps scientists, lab managers, and Biotech and Pharma procurement leaders compare products across vendors, easily source product alternatives, track deliveries, and communicate order status with R&D teams in real-time. ZAGENO makes online shopping for any research material convenient, efficient, and reliable.
















